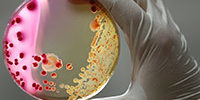

09.11.2018 14:06
Биоимплантаты для устранения дефектов костной ткани будут печатать на 3D-принтере
Группа исследователей из Донского государственного технического университета и Ростовского научно-исследовательского онкологического института разработала технологию создания биоактивных каркасов (скаффолдов) для выращивания долговечных биоимплантатов, которые будут использоваться в реконструктивной хирургии, сообщает РИА Новости.
Проект реализуется научно-исследовательской лабораторией «Инженерные технологии в медицине», являющейся совместным предприятием двух ростовских вузов. По словам руководителя проекта Сергея Чапека, инновационная разработка совмещает применение достижений регенеративной медицины, аддитивных технологий (технологий послойного синтеза или 3D-печати) и система автоматизированного проектирования. Ее внедрение позволит усовершенствовать методики устранения дефектов, полученных пациентами вследствие врожденных патологий, травм или хирургических вмешательств, без использования донорских тканей и органов, что снижает риск заражения и отторжения донорского материала.
Суть технологии заключается в выстраивании посредством 3D-принтера каркаса (скаффолда) из медицинского сплава титана, который затем «заселяется» молодыми клетками костной ткани, полностью соответствующие биомеханическим особенностям поврежденной костной ткани пациента. Таким образом можно создавать биологические имплантаты, которые не будут отторгаться организмом. Титановые скаффолды имеют пористую структуру, при этом размеры, плотность и форму пор можно регулировать в зависимости от нужд пациента.
В настоящее время в лаборатории получены первые образцы скаффолдов. Они отправлены в Ростовский научно-исследовательский онкологический институт, где на их будут «выращивать» фрагменты костной ткани.
Ключевые слова: Биоимплантаты
материал с сайта remedium.ru